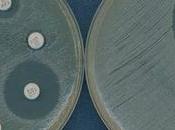
Antibióticos: funcionan laboratorio pero humano

Míriam Lihi
compartido
MIS BLOGS
-
Mis vídeos de salud
http://misvideosdesalud.com/
Vídeos de temas de salud y bienestar.
- Salud y bienestar blog http://saludybienestarblog.com/
ÚLTIMOS ARTÍCULOS (616)
-
Dormir poco hace que nos resfriemos más

Un estudio científico confirma que contra menos horas dormimos y descansamos más propensos somos a resfriarnos Seguramente habéis escuchado que debemos dormir u... Leer el resto
Publicado el 02 septiembre 2015 SALUD Y BIENESTAR -
La verdadera fórmula del amor existe

Hannah Fry elabora la fórmula matemática para el amor duradero o la posible separación de la pareja La fórmula matemática del amor. Leer el resto
Publicado el 02 septiembre 2015 SALUD Y BIENESTAR -
Perder peso con un aparato dental

Un equipo de investigación ha sacado un aparato para la boca que consigue hacernos perder esos kilos de más Esta es sin duda una de las apuestas más llamativas... Leer el resto
Publicado el 02 septiembre 2015 SALUD Y BIENESTAR -
Minerales únicos de nuestro planeta

Un estudio científico asegura que es casi improbable encontrar en otro lugar del universo muchos de los minerales que tenemos en nuestro planeta Muchos de los... Leer el resto
Publicado el 01 septiembre 2015 SALUD Y BIENESTAR -
Embolia pulmonar, estar sentado hace que sea más probable padecerla
Un estudio que ha durado casi 20 años demuestra la importancia de no quedarse muchas horas en una misma posición Pasar demasiado tiempo sentado frente a la... Leer el resto
Publicado el 01 septiembre 2015 SALUD Y BIENESTAR -
Así empezó la vida en la Tierra…

El nacimiento de la vida en la Tierra sigue siendo un misterio para la ciencia pero hoy se ha descubierto una buena clave para saber la respuesta El mecanismo d... Leer el resto
Publicado el 01 septiembre 2015 SALUD Y BIENESTAR -
Se puede curar el cerebro a través de los ojos usando colirios. ¿Lo sabías?

Un nuevo estudio científico abre las puertas a los tratamientos no invasivos de enfermedades que afectan al cerebro Un nuevo estudio científico ha elaborado una... Leer el resto
Publicado el 01 septiembre 2015 SALUD Y BIENESTAR -
La RCP debe durar entre 35 y 53 minutos para ser eficaz

Nuevo estudio científico confirma que para evitar daños y aumentar la probabilidad de supervivencia, una RCP debe durar como mínimo 35 minutos ¿Cuánto debe dura... Leer el resto
Publicado el 01 septiembre 2015 SALUD Y BIENESTAR -
Explicación de porqué a veces no sabemos en qué día vivimos

Nuestra mente asocia cada día de la semana a una sensación o emoción y eso hace que tengamos más o menos percepción del día que es El estudio en cuestión se ha... Leer el resto
Publicado el 01 septiembre 2015 SALUD Y BIENESTAR -
Personas ciegas podrán ver gracias a unas gafas especiales

Hay muchos estudios sobre la ceguera pero este es uno de los que sin duda va a romper con todos los esquemas vistos hasta hoy En Estados Unidos han elaborado... Leer el resto
Publicado el 01 septiembre 2015 SALUD Y BIENESTAR -
Corazón: tiene una buena relación con las proteínas

Consumir ciertos aminoácidos de alimentos vegetales y cárnicos mejora la salud cardiovascular Consumir alimentos ricos en aminoácidos podrían ser tan bueno... Leer el resto
Publicado el 28 agosto 2015 SALUD Y BIENESTAR -
Adelgazar: bebe agua antes de cada comida
Un estudio reciente afirma que el ejercicio, una dieta saludable y beber agua antes de comer ayudan a perder peso Según un estudio científico realizado por... Leer el resto
Publicado el 28 agosto 2015 SALUD Y BIENESTAR -
El dilema de las calorías…
Se abre el debate entre contar o no las calorías de lo que comemos y el tipo de alimentos que elegimos La gente debería dejar de contar calorías y en su lugar... Leer el resto
Publicado el 27 agosto 2015 SALUD Y BIENESTAR -
Cáncer de mama: menos recaídas con un simple análisis de sangre

Se podrán reducir los tratamientos para recaídas de cáncer de mama gracias a la detección (o no) de restos de células cancerosas en sangre Los expertos lo han... Leer el resto
Publicado el 27 agosto 2015 SALUD Y BIENESTAR -
Cosas que decían que ayudaban a envejecer y que ahora se sabe que no hacen nada
Dos estudios confirman que en la tercera edad la actividad física o los suplementos de Omega-3 no ayudan para mejorar la actividad cerebral Desmienten que el... Leer el resto
Publicado el 26 agosto 2015 SALUD Y BIENESTAR -
Medicamento contra el ébola

Favipiravir, es un medicamento que puede haber ayudado a que unos enfermeros británicos no desarrollen la enfermedad tras haberse contagiado Un medicamento que... Leer el resto
Publicado el 26 agosto 2015 SALUD Y BIENESTAR -
Cáncer, ¿será esta la definitiva?

Un estudio de la UTHealth descubre cómo controlar los tumores mediante mecanismos eléctricos Los interruptores moleculares que regulan el crecimiento de... Leer el resto
Publicado el 25 agosto 2015 SALUD Y BIENESTAR -
Otro motivo para consumir menos carne roja

Si comemos más carne roja tenemos más hambre y comemos más, eso da un mayor número de personas con obesidad Los investigadores de Wake Forest Baptist Medical... Leer el resto
Publicado el 25 agosto 2015 SALUD Y BIENESTAR -
Estudio revela que trabajar más de 40 horas semanales aumenta el riesgo de...

Lo ideal es trabajar unas 35 horas y como máximo 40 a la semana, tanto para la empresa como para la salud del trabajador. Una investigación dirigida por Daniel... Leer el resto
Publicado el 25 agosto 2015 SALUD Y BIENESTAR -
Antibióticos: funcionan en el laboratorio pero no en el ser humano
Las pruebas actuales para detectar la eficacia de los antibióticos es limitada y muchas veces errónea Las bacterias son muy astutas. Leer el resto
Publicado el 24 agosto 2015 SALUD Y BIENESTAR
